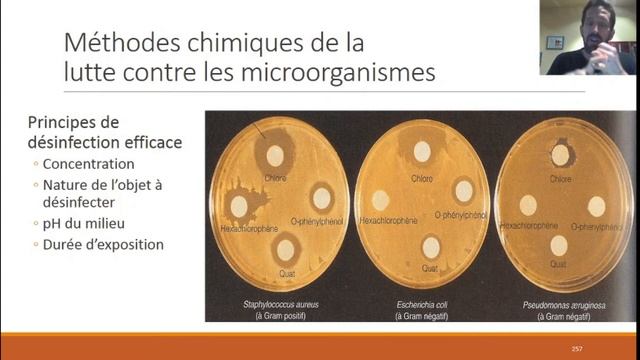
Lutte contre les microorganismes : Cours Microbiologie et immunologie (SI) смотреть онлайн

У
Университетная атмосфера
Смотреть все онлайн видео автора канала
 01:28
01:28
Electron Affinity
 00:06
00:06
Good Morning Ringtone | Message ringtone | message tone | phone ringtone | Only Ringtone
40:24
40:24
Lutte contre les microorganismes : Cours Microbiologie et immunologie (SI)
 28:10
28:10
3-тоқсандық жиынтық бағалауға дайындық.
 08:03
08:03
ML Claude with Yumi wanting to learn Selena.
 07:09
07:09
Argon vs BRAH 6/22 T7 Tournament skirmish
 01:04
01:04
Днёвка на Тунтсайоки
 03:16
03:16
RM TV: Ваксинация за хората над 65 години
 02:36
02:36
i love you like a love song - the divo feat selena gomez
 02:12
02:12
Лизун в домашних условиях без тетроборота натрия #1
 14:51
14:51
07 07 16 Пленарне засідання Київської міської ради ч 12
 40:06
40:06
Mama piernas largas en la vida real. Mama piernas largas bit Selena
 01:03
01:03
Элвин и бурундуки песня
 01:15
01:15
https://www.mediafire.com/file/24pclf4tj8pvmtl/delta_client_10.4.apk/file
 01:00
01:00
Aprea Mare Smeraldo 9 Cabin
 13:29
13:29
Hice un EN VIVO ACCIDENTALMENTE y no me di cuenta.. 😥 *BROMA*
 16:09
16:09
ФОК Чемпион-1- ФК "Академия" (1 тайм)
 06:43
06:43
Smurf cat Skibidi VS Cameraman Titan VS Titan Clock Man VS Photowoman
 00:20
00:20
Alliance Boucheron
 01:40
01:40
MOLECULE ANIMATION DEMO 2015
 10:37
10:37
PAANO MAG DUGTONG NG 70 SQ.MM CABLE ALUMINUM TYPE AND CABLE SPECIFICATION..
 02:01
02:01
SAMP Сериал "Полицейские Будни"
 04:40
04:40
Заморозка орбиз! Классс!!!
 03:37
03:37
Plants VS Zombies 2 - ADVENTURE - Neon Mixtape Tour - Day 15
Страница 1
Вперед →
Рады Вас приветствовать на ruvideo.click, только у нас в кинотеатре у вас есть возможность сделать выбор из огромного количества и посмотреть интересующие онлайн фильмы. Без регистрации, онлайн и при чем совершенно бесплатно вы здесь можете смотреть любой фильм или видео, без отправки смс сообщений и пустой траты денег, все что необходимо это включить и получать удовольствие от просмотра. Лучшего качества видео вы просто не найдете. У нас база видео контента обновляется ежедневно, и это касается не только фильмов, но и сериалов и телепередач. Мировые премьеры как отечественного так и зарубежного кинематографа появляются на сайте одновременно с выходом в прокат. Доброго времени суток и приятного всем просмотра!
Лучше чем онлайн кинотеатр ULTRADOX!